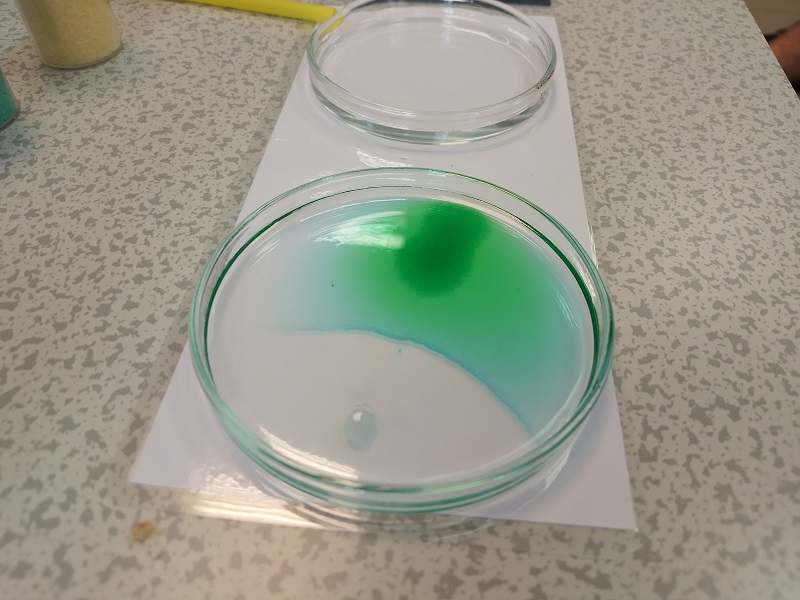

Látványos kísérletekkel várták a Szegedi Tudományegyetem Kémiai Intézetében május 15-én a Bajai III. Béla Gimnázium diákjainak csapatát. A Szent-Györgyi Tanulmányi Versenyhez kötődő laborlátogatásra csatlakoztunk a Bács-Kiskun vármegyéből érkezett fiatalokhoz.
A Bajai III. Béla Gimnáziumból érkezett egy 14 fős diákcsoport 2025. május 15-én a Szegedi Tudományegyetemre. Látogatásukat a József Attila Tanulmányi és Információs Központban kezdték, ahol megtekintették a Karikó Katalin útja a Nobel-díjig és tovább című kiállítást, majd átsétáltak a Dóm térre, az SZTE Kémiai Intézetbe, ahol látványos, érdekes kísérleteket próbálhattak ki párokba rendeződve. A bajai diákok két kísérővel jöttek, Lakner Attila matematika-fizika szakos tanár és Masa György biológiatanár vezette a 11. osztályosokból álló csoportot. Elmondták, a tavalyi Szent-Györgyi Tanulmányi Versenyre (SZGYTV) háromfős csapattal érkeztek, közülük ketten éppen most érettségiztek, ezért csak egy versenyző tudott eljönni a laborgyakorlatra. A 2024-es versenyen elért eredmény alapján kapott az iskola meghívást, hogy részt vehet egy egésznapos programon a Szegedi Tudományegyetem szervezésében.
A laboratóriumban Dr. Musza Katalin, a Kémiai Intézet tudományos munkatársa, az SZGYTV szakmai munkacsoportjának tagja várta a fiatalokat, minden szükséges anyag és eszköz elő volt készítve a rendhagyó tanórához. Egy rövid balesetvédelmi eligazítás után különböző típusú, színes, érdekes kémiai reakciókat idézhettek elő a diákok. Az úgynevezett fekete kígyó kísérlettel melegítettek be, amely egy hőbomlással járó folyamat.
                       |
| Bajai gimnazisták kísérleteztek az SZTE Kémiai Intézetben. Képgaléria: Vida-Szűcs Imre |
A folytatásban csapadékképződési reakciókat vizsgáltak. Petri-csészékbe öntöttek desztillált vizet, majd megnézték, milyen az, amikor a vízben oldódó anyagokból az oldatfrontok összeérnek, és csapadék keletkezik.
– Hallottatok-e a karbidlámpáról? Ezt bányászok használták régen, és a 2010-es évekig a barlangászok is – mondta Dr. Musza Katalin, majd megmutatta egy fotón, hogy néz ki a karbidlámpa. – Ennek a tárolójába tettek kalcium-karbid nevű anyagot, erre folyamatosan vizet csepegtettek. A keletkező gáz (acetiléngáz) egy kis csövön kijött, azt egyszerűen meggyújtották, és azzal világítottak a bányában. Ma már ennél sokkal modernebb módszereket tudnak használni, ezért kiment a divatból. Most megnézzük, hogy is működött a karbidlámpa – vezette fel a kísérletet.
Miután mindenki végzett az acetilén „gyújtogatással”, redoxireakciót néztek meg. Ehhez egy-egy gumimacit áldoztak be. – Nem kóstolásnak van, mert ugye elmondtam, hogy a laborban semmit nem kóstolunk meg! A kémcsőben a lila színű oldat kálium-permanganát. Ebbe tegyétek bele a gumimacit. Nem fog robbanni, kiugrani, semmi ilyesmitől ne féljetek! Türelmesen figyeljétek a kémcsövet, nézzétek, hogy mi történik! – adta az instrukciókat a laborgyakorlat vezetője, akit egyetemi hallgatók segítettek, hogy minden diákpárosra jusson egy-egy „felügyelő”.

Az utolsó kísérletben a bajai gimnazisták kínafa kérgéből vonták ki a kinint. Hogy sikerrel jártak-e, azt UV-lámpa alatt ellenőrizték, ugyanis a kinin a lámpa alatt elszíneződik. Dr. Musza Katalin megjegyezte, Dél-Amerikában a bennszülöttek rájöttek, hogy lázcsillapításra nagyon jó, malária elleni gyógyszerként használták sokáig. A kínafa kérgéből készítettek főzetet, azt adták a betegeknek. Később a gyarmatosítók megelőzés céljából is itták ezt. A gyarmaton lévő katonáknak ez a főzet túlságosan keserű volt, így megpróbálták valamilyen módon ihatóvá tenni. Az urbánus legenda szerint ginbe keverve fogyasztották. Talán innen datálható gin-tonik. „Hogy ez mennyire igaz vagy sem, annak járjatok utána!” – hangzott a javaslat.
– Szerintem nagyon hasznos és érdekes volt a program. Azt hittem, hogy keveset fogok tudni hozzászólni ehhez a mostani kémiatudásommal, de értettem a folyamatokat, hogy mi történik kísérletezés közben – mondta Bednárik Hanna. – A Karikó Katalint bemutató kiállítást is érdekesnek találtam, nem tudtam, hogy a tudós Szegeden járt egyetemre. Nagyon tetszett, hogy interaktív a tárlat – tette hozzá.
A diákcsoportot ebéd után a 3D központba várták, ahol a 3D nyomtatás és telemedicina az orvoslásban témájában hallgathattak előadást az SZTE oktatóitól. Ezzel zárult az élménydús program, amelyet a Szent-Györgyi Tanulmányi Versenyhez kapcsolódóan kapott ajándékba a III. Béla Gimnázium.
Szöveg és fotó: Vida-Szűcs Imre